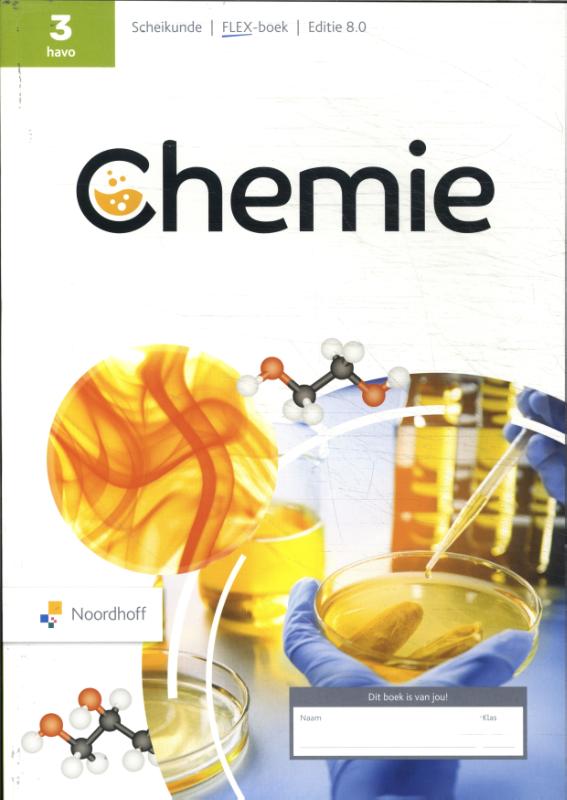
Flex-boek

Laden...
In het kort
Samenvatting
Over de kunst van het kijken naar vogels, en het ontdekken van het leven.
In het kort
Over de kunst van het kijken naar vogels, en het ontdekken van het leven.
Specificaties
Auteur
Jean-Pierre Geelen
Uitgever
Atlas Contact, Uitgeverij
Taal
Nederlands
Aantal pagina's
184
Ondertitel
Hoe ik leerde vogels kijken
Formaat
Paperback
Publicatiedatum
5 februari 2018
ISBN
9789046706718
Wij helpen je graag!
Kom je er niet direct uit? Wij helpen je graag met al jouw vragen.
Misschien vind je deze boeken ook leuk...
Leuk om te lezen naast "Blinde vink"